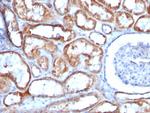
Mitochondria (Marker for Human Cells, Granular RCC s and Salivary Tumor Antibody in Immunohistochemistry (Paraffin) (IHC (P))

Search
NeoBiotechnologies
Mitochondria (Marker for Human Cells, Granular RCC s and Salivary Tumor Monoclonal Antibody (113-1)
{{$productOrderCtrl.translations['antibody.pdp.commerceCard.promotion.promotions']}}
{{$productOrderCtrl.translations['antibody.pdp.commerceCard.promotion.viewpromo']}}
{{$productOrderCtrl.translations['antibody.pdp.commerceCard.promotion.promocode']}}: {{promo.promoCode}} {{promo.promoTitle}} {{promo.promoDescription}}. {{$productOrderCtrl.translations['antibody.pdp.commerceCard.promotion.learnmore']}}
产品信息
MSM1-739-P0
种属反应
宿主/亚型
分类
类型
克隆号
抗原
偶联物
形式
浓度
规格
纯化类型
保存液
内含物
保存条件
运输条件
产品详细信息
Does not react with Mouse or Rat
靶标信息
Antibodies that recognize subcellular organelles or compartments of human cells are useful in identification of these organelles in cells, tissues, and biochemical preparations. Anti-mitochondria antibodies can be used to stain mitochondria in cell/tissue preparations and can be used as a marker in subcellular fractions.
仅用于科研。不用于诊断过程。未经明确授权不得转售。